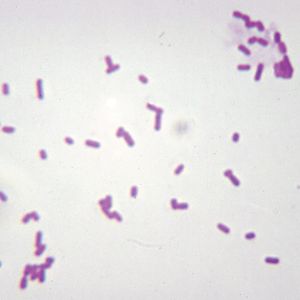
Real World Classroom Connections Hospital Acquired Infections And Super Bugs Carolina Com

[10000印刷√] e coli microscope slide 764738-E coli microscope slide
Escherichia coli and Staph aureus ()jpg 2,160 × 1,440;The prepared microscope slide image of Bacillus Subtilis at left was captured at 400x magnification Learn more here E Coli E Coli under the microscope at 400x E Coli (Escherichia Coli) is a gramnegative, rodshaped bacterium Most E Coli strains are harmless, but some serotypes can cause food poisoning in their hostsE coli is a Gramnegative rodshaped bacteria When Gram stained, the organism looks pink or red Here are a couple of pictures of a Gram stain of E coli that I did under the 100X objective lens on a standard light microscope You can of course
Polymers For Binding Of The Gram Positive Oral Pathogen Streptococcus Mutans
E coli microscope slide
E coli microscope slide-The prepared microscope slide image of Bacillus Subtilis at left was captured at 400x magnification Learn more here E Coli E Coli under the microscope at 400x E Coli (Escherichia Coli) is a gramnegative, rodshaped bacterium Most E Coli strains are harmless, but some serotypes can cause food poisoning in their hostsAllow students to explore the morphology of 1 of the most wellknown, Gramnegative bacteria, E coli This rodshaped, facultative anaerobe is normally present in the intestines of warmblooded animals However, it can be pathogenic This slide works well when discussing harmful and helpful bacteria


Polymers For Binding Of The Gram Positive Oral Pathogen Streptococcus Mutans
You make a smear of E coli and then simple stain the slide with methylene blue If you failed to use correct aseptic technique by not sterilizing the loop picking up the bacterial sample for the smear, what results may be seen under the microscope?E coli resuspended in LBmedium were placed between slide and coverslip and sealed with nailpolish 23 Singlephoton confocal microscopyA standard beam scanning microscope (Leica TCS SP, Leica Lasertechnik, Heidelberg, Germany) with adjustable bandwidths of the detected fluorescence wavelengths was used479 KB Escherichia coli flagella TEMpng 600 × 6;
Characterization of serine metabolism in E coli E coli synthesizes serine through either two glycine or one 3phosphoglycerate (Supplementary Fig 1A)In the glycine route, one glycine is firstE coli 1 PRESENTED BY NOMAN HAFEEZ KHOSA ABDUL SAMI FARHAN MISBAH SADIQ ANUM AJMAL Escherichia coli 2 2 Esherichia coli Gramnegative rod Facultative anaerobe Named for Theodor Escherich German physician (ca 15) Demonstrated that particular strains were responsible for infant diarrhea and gastroenteritis Normal flora of the mouth and intestine Protects the intestinal tract from bacterialE coli flagella have previously been known to adhere to certain proteins on the surface of cells in the gut wall, indicating that the bacteria are capable of bonding with specific molecular matches But in the 1970s, biologists observing E coli on microscope slides had also seen something curious bacteria wheeling about under the coverslip
Observation When viewed under theA bacterial species with catalase activity produces bubbles of oxygen when hydrogen peroxide is added to the bacterial smear on a microscope slide Bacterial species such as Staphylococci , Salmonella , and E coli are catalasepositive, while Streptococcus is a catalasenegativeThe slide is stained with safranin for 1min, then rinse with water very gently until no color is coming from the water Blot dry with absorbent paper Place the slide on the microscope to view the sample The grampositive bacteria will stain dark blue or purple The gramnegative bacteria will stain pink In this figure A procedure of Gram stain


Lab 1



Gram Stain Demonstration Slide 400x 1 Marc Perkins Photography
E coli is the normal flora of the human body;Escherichia coli Four different strains of Escherichia coli on Endo agar with biochemical slope Glucose fermentation with gas production, urea and H 2 S negative, lactose positive (with exception of strain D "late lactose fermenter";Eisco™ Prepared Microscope Slide Escherichia Coli Smear, Gram Stain Prepared microscope slide of Escherichia Coli smear Manufacturer Eisco™ BS Catalog No S296 $305 / Each;


Polymers For Binding Of The Gram Positive Oral Pathogen Streptococcus Mutans


Lab 1
Escherichia coli (/ ˌ ɛ ʃ ə ˈ r ɪ k i ə ˈ k oʊ l aɪ /), also known as E coli (/ ˌ iː ˈ k oʊ l aɪ /), is a Gramnegative, facultative anaerobic, rodshaped, coliform bacterium of the genus Escherichia that is commonly found in the lower intestine of warmblooded organisms (endotherms) Most E coli strains are harmless, but some serotypes (EPEC, ETEC etc) can cause serious foodEisco Prepared Microscope Slide Escherichia Coli Smear Gram Asmscience Examination Of Gram Stains Of Urine Gram Stain Tissue Trol Control Slides From Mouse Lung Tissue Gram Stain Of E Coli Bacterium A Gram Stain Of Shows Escherichia Coli Slide W M Science Lab Microbiology SuppliesEscherichia coli Gram stained smear under microscopeRod shapedpink in colorthat's why Gram negative Bacilli#GramStain#GNB#GNR


Biol 230 Lab Manual Lab 1
/gram-positive-staphylococcus-aureus-bacteria-541802136-57979cca5f9b58461f26eccc.jpg)


Gram Stain Procedure In Microbiology
The niche of E coli depends upon the availability of the nutrients within the intestine of host organisms;Microscope slide of three types of bacteria Cocci are spherical or oval in shape Bacillus are rodshaped Spirillum are spiral shaped E Coli Escherichia Coli is a rodshaped bacterium that is commonly found in the lower intestine of warmblooded organisms Most strains are harmlessGram Stained Slides (Click on image to enlarge) Gram stained slides, showing & bacterial controls on left and right circles of slide and unknown bacteria in center Grampositive Bacteria Under Microscope


Www Jfmed Uniba Sk Fileadmin Jlf Pracoviska Ustav Mikrobiologie A Imunologie Enterobacteriaceae Campylobacter Helicobacter Pdf



Microscopes Equipment Microscope Accessories Escherichia Coli Intestinal Flora Microscope Slide Viventodvere Sk
A) No cells may be visible on the slide1 Escherichia coli is a Gram negative, facultative anaerobic, rodshaped bacteria It is a commensal that is found inhabiting the lower intestine of warm blooded animals A small proportion of E coli strains are pathogenic The harmless strains produce vitamin K and prevent colonization of the intestine by pathogenic bacteria E coli is classified into serotypes based on cell wall (O), capsular (K), fimbrial (F) and flagellar (H) antigensThe genus Salmonella is closely related to Escherichia coli bacteria and is suggested to have diverged from the bacteria (E coli) about 150 million years ago Use a tissue paper to remove excess water by touching the sides of the slide;


Escherichia Coli Light Microscopy


Files Eric Ed Gov Fulltext Ej8704 Pdf
The Best E Coli Microscope of 21 – Reviewed and Top Rated After hours researching and comparing all models on the market, we find out the Best E Coli Microscope of 21 Check our ranking below 2,9 Reviews ScannedMicroscope escherichia coli gram stain e coli Gram Stain E Coli Microscope Written By MacPride Tuesday, July 23, 19 Add Comment Edit Puzzlepix Figure 1 From Detection Of Multidrug Resistant And Shiga Toxin Escherichia Coli Slide W M Science Lab Microbiology SuppliesView the slide under the microscope starting with lower power;



Slide Escherichia Coli


Biol 230 Lab Manual Lab 1
The Best E Coli Microscope of 21 – Reviewed and Top Rated After hours researching and comparing all models on the market, we find out the Best E Coli Microscope of 21 Check our ranking below 2,9 Reviews ScannedInstead, their genetic material floats uncoveredEscherichia coli and Staph aureus ()jpg 2,160 × 1,440;



The Water Pollution Problems And Results English Slides W Joh Lieder Gmbh Co 4540 En English 3b Scientific



Bacterial Staining Microbiology Images Photographs And Videos Of Gram Acid Fast Endospore
The prepared microscope slide image of Bacillus Subtilis at left was captured at 400x magnification Learn more here E Coli E Coli under the microscope at 400x E Coli (Escherichia Coli) is a gramnegative, rodshaped bacterium Most E Coli strains are harmless, but some serotypes can cause food poisoning in their hostsTHE PROCEDURE done individually We have cultures of E coli and Bacillus for you to gram stainThis will give you gram and gram – controls to check your procedure against You can use 2 slides, 1 for each bacterium, or you can divide one slide in half and smear each bacterium on the divided slideEscherichia coli Escherichia coli is a small bacillus Estimate the length and width of a typical rod c Treponema pallidum Treponema pallidum is a spirochete a thin, flexible spiral On this slide you are examining a direct stain ofTreponema pallidum, the bacterium that causes syphilis Measure the length and width of a typical spirochete



Pin On E Coli



Escherichia Coli Lecture
Prepared microscope slide of Escherichia coli, bacilli, smear Description This slide of a smear of E coli is best viewed under a microscope with an oilimmersion objective Qty 1 slideSingle, prepared slide with Escherichia Coli smear Slide measures 75mm wide and 25mm long Excellent for examination and discussion about pathogenic and nonpathogenic bacteria Wholemount Gram stain Arrives in a protective cardboard casing263 MB Escherichia coli electron microscopyjpg 800 × 640;



Microscopy And Staining



Escherichia Coli Colony Morphology And Microscopic Appearance Basic Characteristic And Tests For Identification Of E Coli Bacteria Images Of Escherichia Coli Antibiotic Treatment Of E Coli Infections
Qty Add to cart Description;Direct counting using a PetroffHausser counting chamber It's feasible to count the number of colonies479 KB Escherichia coli flagella TEMpng 600 × 6;



Pin On Microbiology



Bacteria Under The Microscope E Coli And S Aureus Youtube
Description Precleaned glass slide with ground edges Professionally stained samples for best visualization Ideal for biology classrooms to explore structurefunction relationships as per NGSS standards Showing gram negative E Coli bacteria stained with carbolfuchsinSingle, prepared microscope slide of Escherichia Coli (EColi) Wholemount, stained with Gram Stain EColi is a gramnegative bacterium, most commonly found in the digestive system of mammals While it is not typically harmful, the bacteria may become pathogenic Excellent for discussion about pathogenic vs nonpathogenic bacteriaE coli was discovered by Theodor Escherich in 15 after isolating it from the feces of newborns;



Prepared Microscope Slides Vwr



Industrial Scientific Smear Microscope Slide Entamoeba Histolytica Trophozoites Microscope Sample Slides
Place the slide on microscope and view the sample When viewed under the microscope, Gramnegative E Coli will appear pink in color The absence of this (of purple color) is indicative of Grampositive bacteria and the absence of Gramnegative E ColiEscherichia coli colonies on eosinmethylene blue agar will have a characteristic green metallic sheen that other gramnegative bacteria will not have Which technique requires visualization of the bacteria on a slide using a microscope?Prepared microscope slide of Escherichia coli, bacilli, smear Description This slide of a smear of E coli is best viewed under a microscope with an oilimmersion objective Qty 1 slide


Microbiology Lab Exercise 10 Smear Preparation Exercise 11 Simple Staining Ex 12 Negative Staining Review Lab Results From Last Week Ex 8 Aseptic Technique Did You Successfully Get Bacteria Growing In Your Broth And Slant Ex 6 The


Pathogenic E Coli
27 Earth BacteriaE coli For comparison with the possible martian microfossils (slide #26), this slide shows an electron microscope view of a common Earth bacterium, prepared the same way as the possible martian microfossilsThe many rods and sausage shapes here are individual cells of the bacterium Escherichia coli, or E coli for short1 Escherichia coli a Fix a smear of Escherichia coli to the slide as follows 1First place a small piece of tape at one end of the slide and label it with the name of the bacterium you will be placing on that slide 2Using the dropper bottle of deionized water found in your staining rack, place 1/2 of a normal sized drop of water on a clean slide by touching the dropper to the slideEscherichia coli (/ ˌ ɛ ʃ ə ˈ r ɪ k i ə ˈ k oʊ l aɪ /), also known as E coli (/ ˌ iː ˈ k oʊ l aɪ /), is a Gramnegative, facultative anaerobic, rodshaped, coliform bacterium of the genus Escherichia that is commonly found in the lower intestine of warmblooded organisms (endotherms) Most E coli strains are harmless, but some serotypes (EPEC, ETEC etc) can cause serious food



What Does An E Coli Bacteria Look Like Under A Microscope Quora
-lab-2063642447.jpg)


Microscope Slides Microscope Slides India Microscope Slides Manufacturer Microscope Slides Suppliers And Microscope Slides Exporter In India Microscope Slides School Lab
Escherichia coli or Ecoli is a gramnegative species of bacillus shaped bacteria that can be easily observed under a microscope, even for those with the untrained eye This bacteria has a fast growth rate, doubling every minutes, making them a common choice for bacterial related research purposesBiology Of E Coli E coli (Escherichia coli) are a small, Gramnegative species of bacteriaMost strains of E coli are rodshaped and measure about μm long and 0210 μm in diameterThey typically have a cell volume of 0607 μm, most of which is filled by the cytoplasm Since it is a prokaryote, E coli don't have nuclei;On Endo agar it looks like lactose negative)All four strains are mannitol positive (best seen in fig D), cellobiose negative (strains A, B)



Biofilm Formation By E Coli Strains On A Microscope Slides Lb Download Scientific Diagram



9 Gram Staining Best Practices Microbiologics Blog
Flood acetonealcohol quickly on the slide, and wash off within 510 seconds (from beginning of decolorizer added) Wash WELL with water Flood the smear with drops of safrinin, leaving in for 1 minute Wash WELL with water Blot dry with bibulous paper before placing on microscope stage to view27 Earth BacteriaE coli For comparison with the possible martian microfossils (slide #26), this slide shows an electron microscope view of a common Earth bacterium, prepared the same way as the possible martian microfossilsThe many rods and sausage shapes here are individual cells of the bacterium Escherichia coli, or E coli for shortMicroscope slide of three types of bacteria Cocci are spherical or oval in shape Bacillus are rodshaped Spirillum are spiral shaped E Coli Escherichia Coli is a rodshaped bacterium that is commonly found in the lower intestine of warmblooded organisms Most strains are harmless


Microscope Slide Escherichia Coli Microslides Viewers Slides Microscopes Magnification Lab Equipment Supplies Education Supplies Nasco



2 4 Staining Microscopic Specimens Biology Libretexts
263 MB Escherichia coli electron microscopyjpg 800 × 640;The primary habitat of E coli is in the gastrointestinal (GI) tract of humans and many other warmblooded animalsAllow students to explore the morphology of 1 of the most wellknown, Gramnegative bacteria, E coli This rodshaped, facultative anaerobe is normally present in the intestines of warmblooded animals However, it can be pathogenic This slide works well when discussing harmful and helpful bacteria


Biol 230 Lab Manual Lab 1



Photobleaching During Fluorescence Microscopy Imaging E Coli Jm109 Download Scientific Diagram
Now that the slide has been heat fixed, you may now begin to stain the organism This is started by applying a few drops of crystal violet for 30 seconds, then rinsing with water for 5 seconds Next, cover the slide with Gram's Iodine and let sit for a full minute before rinsing with water for another 5 secondsEscherichia Coli Sm Microscope Slides Zhangjiagang Leyu Insight Into Why E Coli Sickness Levels Vary Evidence Of Multi Domain Morphological Structures In Living Closer To The End Of Intestinal Infections By Escherichia Coli E Coli Under A Scanning Electron Microscope Image EurekalertYou inoculate a sterile broth with E coli but after 48 hours of incubation at 37 degrees Celsius, the medium remains clear Using the loop, you disperse the bacteria into the water drop on the microscope slide Why is it important to air dry the bacteria before they are immobilized by heat fixation?



Staining Microscopic Specimens Microbiology



Asmscience Examination Of Gram Stains Of Urine
Fix a smear of either Escherichia coli, Pseudomonas aeruginosa, or Klebsiella aerogenes to the slide as follows 1 First place a small piece of tape at one end of the slide and label it with the name of the bacterium you will be placing on that slideYou make a smear of E coli and then simple stain the slide with methylene blue If you failed to use correct aseptic technique by not sterilizing the loop before picking up the bacterial sample for the smear, what results may be seen under the microscope?



Escherichia Coli E Coli An Overview Microbe Notes



E Coli Under The Microscope Types Techniques Gram Stain Hanging Drop Method


Q Tbn And9gcqkye60ou Johpr02n Mbv1fferrjpdh Lnct7ymdf5qhyia1ld Usqp Cau



Escherichia Coli Don Xavier N D Morphology Gram Negative Oxidase Negative Non Sporing Non Capsulated Bacillus Strains Of E Coli Are Usually Motile Ppt Download


What Does An E Coli Bacteria Look Like Under A Microscope Quora



Propidium Iodide Staining Underestimates Viability Of Adherent Bacterial Cells Scientific Reports



Gram Staining Principle Procedure And Results Learn Microbiology Online



Microscopic Slides Flashcards Quizlet



Bacterial Slides Bacerial Stains Microbiology


Biol 230 Lab Manual Lab 1



B8a Prepared Microscope Slide Escherichia Coli W M Findel Education



E Coli Under The Microscope Types Techniques Gram Stain Hanging Drop Method

Real World Classroom Connections Hospital Acquired Infections And Super Bugs Carolina Com



Bacteria Types Slide Separate Smears Gram Stain Science Lab Microbiology Supplies Amazon Com Industrial Scientific



Biol 51 Lab Midterm Flashcards Quizlet



Staining Microscopic Specimens Microbiology



Bacteria Under The Microscope Microscope And Laboratory Equipment Reviews



E Coli



100pcs Set Microscope Slides Biological Glass Sample Prepared Basic Animal Plants Insects Tissues Science Specimen Cover Slips Microscope Parts Accessories Aliexpress



Bacterial Staining Microbiology Images Photographs And Videos Of Gram Acid Fast Endospore



10pk Escherichia Coli Smear Gram Stain Prepared Microscope Slides 75 X 25mm Classroom Pack 10 Slides In Storage Case Biology Microscopy Eisco Labs Amazon Com Industrial Scientific



Enhanced Propagation Of Motile Bacteria On Surfaces Due To Forward Scattering Nature Communications



Observing Bacteria Under The Light Microscope Microbehunter Microscopy



Biofilm Formation By E Coli Strains On A Microscope Slides Lb Download Scientific Diagram



Tech Tip Imaging Bacteria Using Agarose Pads Biotium



2 3 Instruments Of Microscopy Microbiology Canadian Edition



Gram Stain Microbiology Images Photographs


Microscope Slide Escherichia Coli Microslides Viewers Slides Microscopes Magnification Lab Equipment Supplies Education Supplies Nasco



Simple Stain Results


Biol 230 Lab Manual Lab 1



Bacterial Staining Microbiology Images Photographs And Videos Of Gram Acid Fast Endospore


Http Coltonanderson1 Weebly Com Uploads 2 4 3 0 Manual Pdf



Staining Microscopic Specimens Microbiology


Www Mccc Edu Hilkerd Documents Bio1lab3 Exp 4 Pdf



Bacterial Staining Microbiology Images Photographs And Videos Of Gram Acid Fast Endospore



Complete Genome Sequence Of Escherichia Coli C An Old Model Organism With A New Application In Biofilm Research Biorxiv



A Well Mixed E Coli Genome Widespread Contacts Revealed By Tracking Mu Transposition Sciencedirect



Individual Escherichia Coli Mancha Vidrio Preparado Microscopio Microbiologia Diapositivas Buy Diapositivas De Microbiologia Medica Escherichia Coli Frotis Diapositivas Preparadas De Microbiologia Product On Alibaba Com


Q Tbn And9gcswouuht13c4cxzkdgvwicdnmwhgkfjwlh40a Eerzzlpwjtmyt Usqp Cau



Solved Look At The 2 Gram Stain Slide This Is A Gram Sta Chegg Com



Solved Look At The 2 Gram Stain Slide This Is A Gram Sta Chegg Com



Staining Microscopic Specimens Microbiology


Www Mccc Edu Hilkerd Documents Bio1lab3 Exp 4 Pdf



Observing Bacteria Under The Microscope Gram Stain Steps Rs Science


Www Jfmed Uniba Sk Fileadmin Jlf Pracoviska Ustav Mikrobiologie A Imunologie Enterobacteriaceae Campylobacter Helicobacter Pdf



Gram Stain 10pk Escherichia Coli Smear Eisco Labs Classroom Pack 10 Slides In Storage Case 75 X 25mm Prepared Microscope Slides Biology Microscopy


What Does An E Coli Bacteria Look Like Under A Microscope Quora


Q Tbn And9gcqkye60ou Johpr02n Mbv1fferrjpdh Lnct7ymdf5qhyia1ld Usqp Cau


Files Eric Ed Gov Fulltext Ej8704 Pdf


Biol 230 Lab Manual Lab 1



Solved Look At The 2 Gram Stain Slide This Is A Gram Sta Chegg Com


Q Tbn And9gcss8nmc1pd 9ek0jtmelxjs27uwjf4hgozn8edtzxrq6dobbmj7 Usqp Cau


What Does An E Coli Bacteria Look Like Under A Microscope Quora



A Control A Slide Showing Intact Rod Shaped E Coli 0157 H7 Cells And Download Scientific Diagram



Observing Bacteria Under The Light Microscope Microbehunter Microscopy


Www Dechra Us Com Files Files Supportmaterialdownloads Us Us 077 Pra Pdf



Gram Stain Wikipedia



How E Coli Bacteria Look Like



Slides Show



Gram Staining Principle Procedure Interpretation Examples And Animation



Bacteriology Prepared Microscope Slides



Phenotypic Plasticity Of Escherichia Coli Upon Exposure To Physical Stress Induced By Zno Nanorods Scientific Reports



Eiscoprepared Microscope Slide Escherichia Coli Smear Gram Stain Microbiology Fisher Scientific



3b Water Pollution Our Environm Microscope Slides Set Of



10pk Escherichia Coli Smear Gram Stain Prepared Microscope Slides 75 X 25mm Classroom Pack 10 Slides In Storage Case Biology Microscopy Eisco Labs Amazon Com Industrial Scientific



Escherichia Coli Slide W M Science Lab Microbiology Supplies Amazon Com Industrial Scientific


Pathogenic E Coli



Eiscoprepared Microscope Slide Escherichia Coli Smear Gram Stain Microbiology Fisher Scientific


Staphylococcus Aureus And Ecoli Under Microscope Microscopy Of Gram Positive Cocci And Gram Negative Bacilli Morphology And Microscopic Appearance Of Staphylococcus Aureus And E Coli S Aureus Gram Stain And Colony Morphology On Agar Clinical



Solved A In A Study Involving E Coli Bacteria A Certa Chegg Com


コメント
コメントを投稿